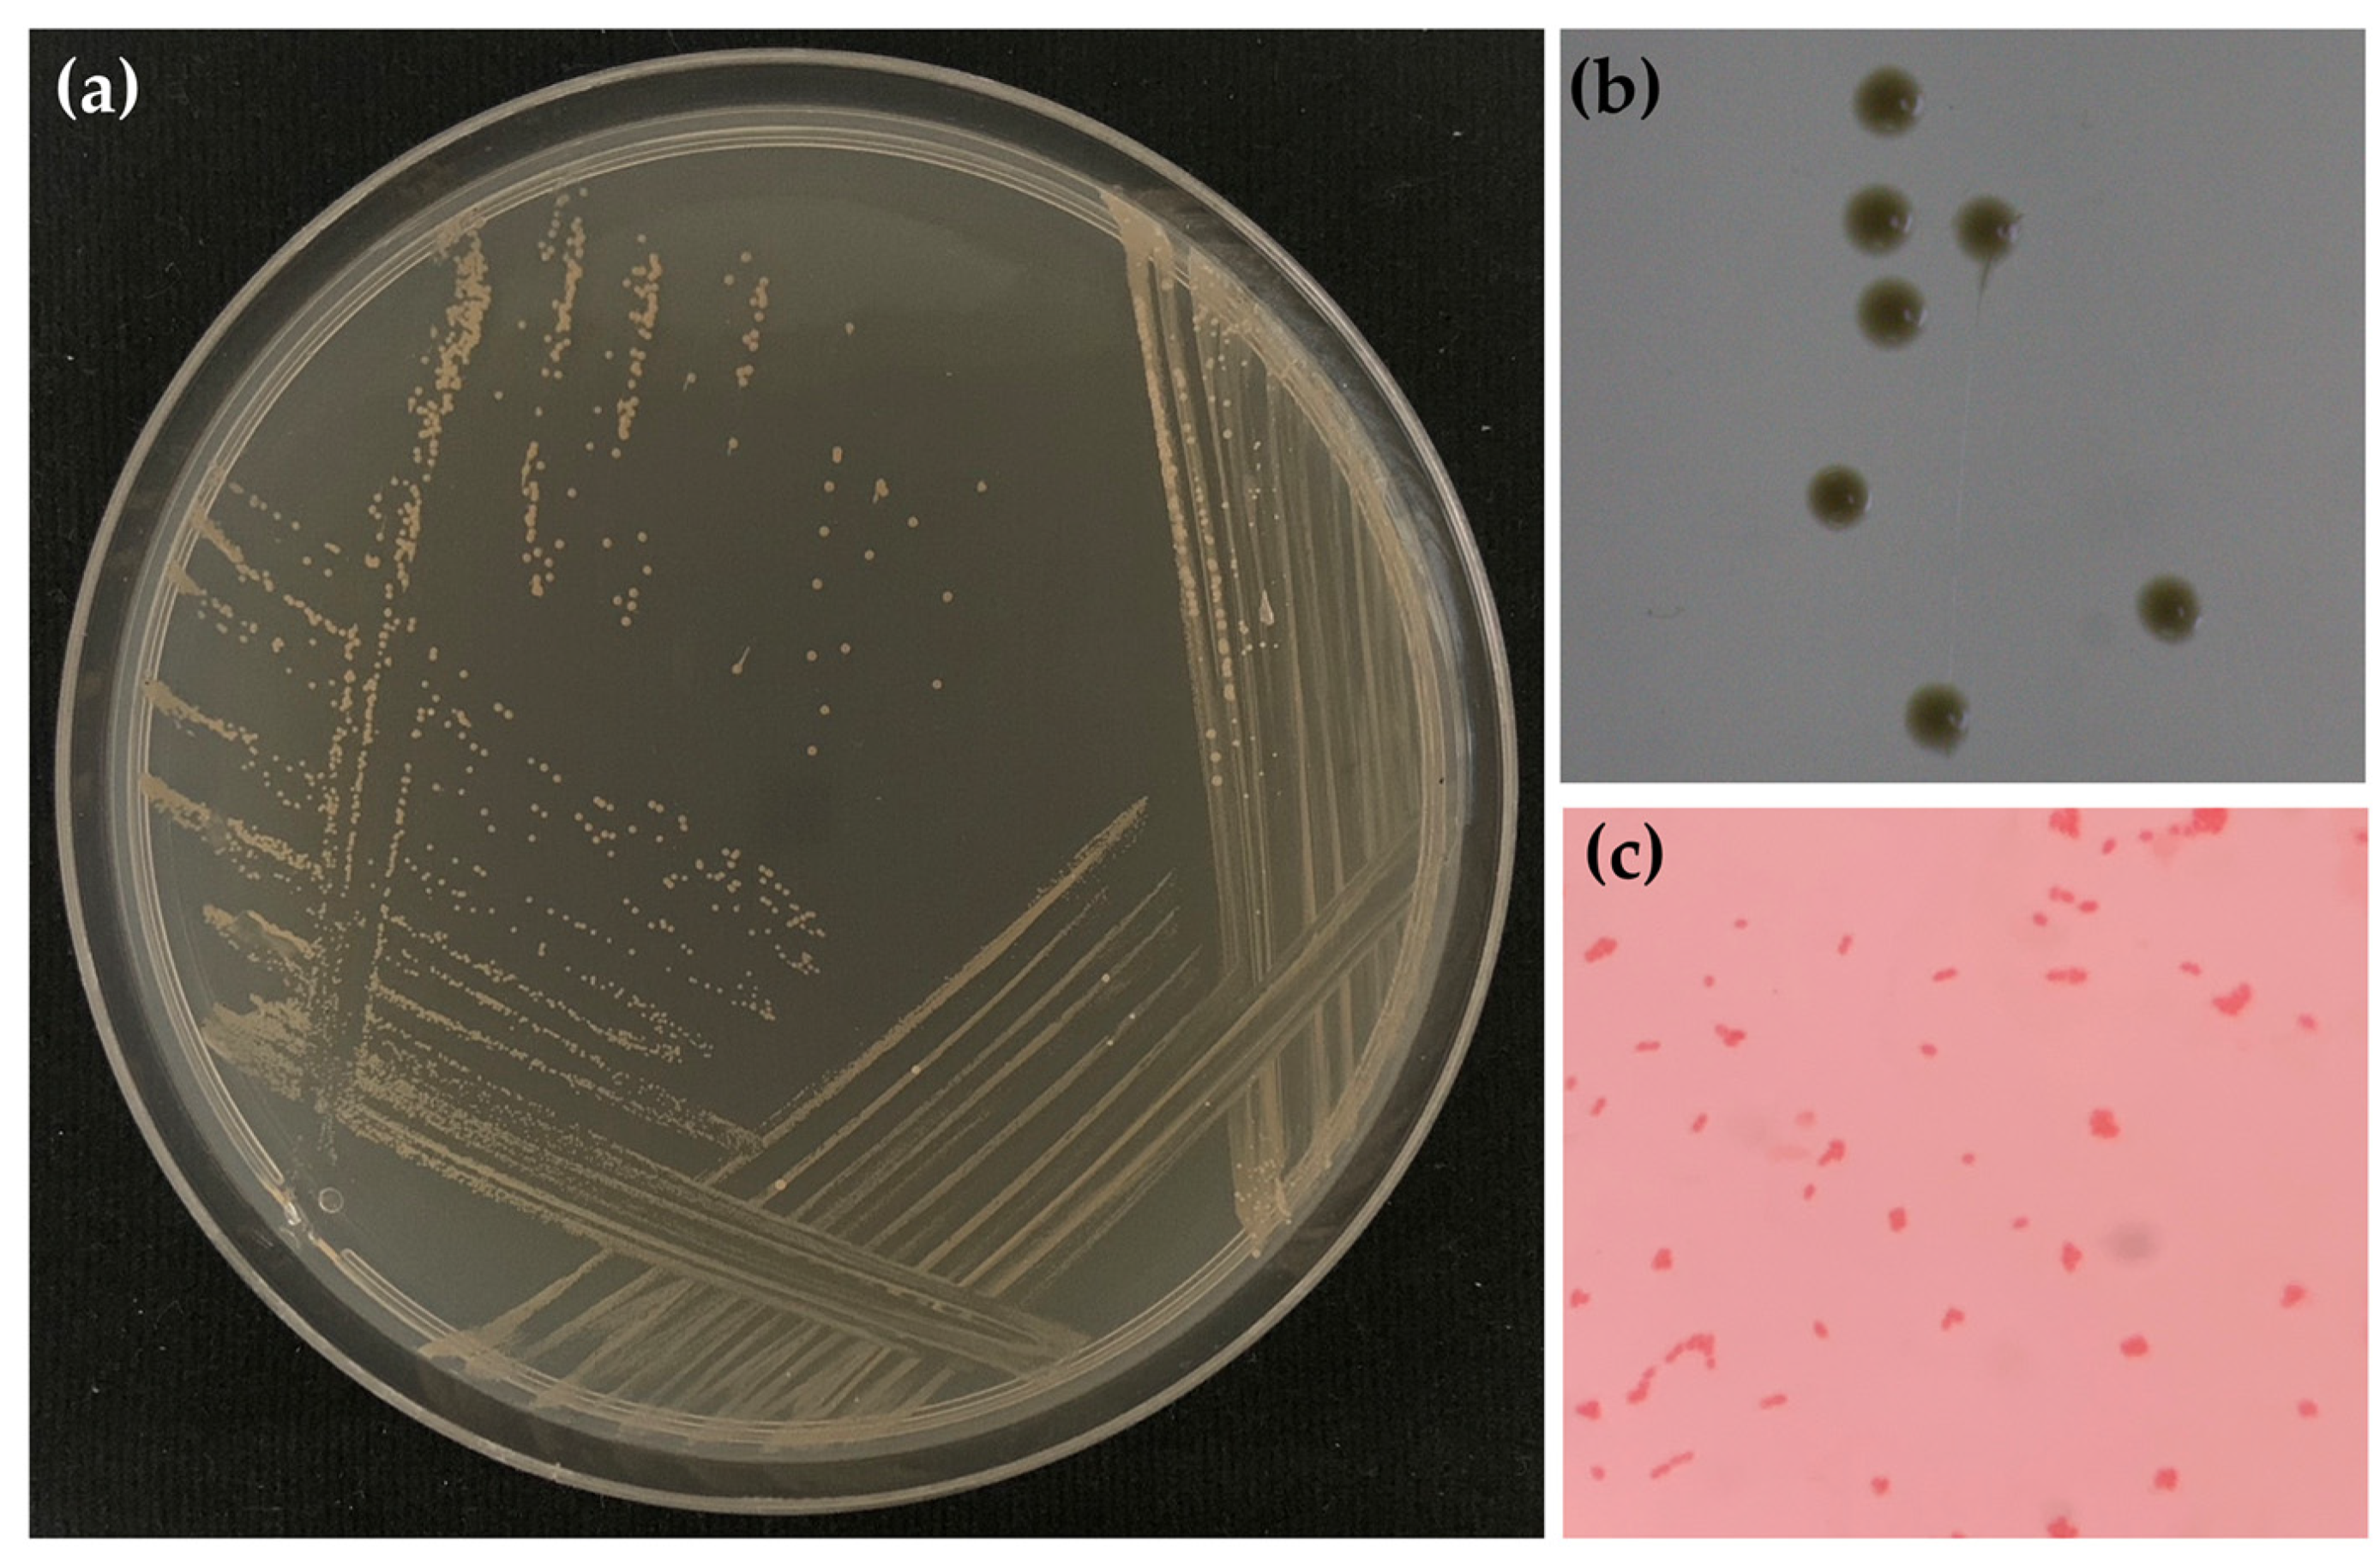
Gels 09 00816 g004

Development of Film-Forming Gel Formulations Containing Royal Jelly and Honey Aromatic Water for Cosmetic Applications
Abstract
:1. Introduction
2. Results and Discussion
2.1. Honey Aromatic Water
2.2. Sterilization Process of Honey Aromatic Water
2.3. Stability Test of Honey Aromatic Water
2.4. Irritation Potency of Honey Aromatic Water
2.5. Film-Forming Gel Base
2.6. Film-Forming Gel Containing Honey Aromatic Water with and without Royal Jelly
3. Conclusions
4. Materials and Methods
4.1. Honey Aromatic Water
4.2. Chemical Materials
4.3. Sterilization Process of Honey Aromatic Water
4.3.1. Filtration
4.3.2. Autoclave
4.4. Characterization of Honey Aromatic Water
4.5. Stability Test of Honey Aromatic Water
4.5.1. Storage Conditions
4.5.2. Characterizations
4.5.3. Microbial Counts Analysis
4.6. Irritation Test by Hen’s Egg Test–Chorioallantoic Membrane (HET-CAM) Assay
4.7. Development of Film-Forming Gel Base
4.7.1. Preparation of Film-Forming Gel Base
4.7.2. Characterizations of Film-Forming Gel Base
- External appearances
- Viscosity measurement
- Spreadability measurement
- pH measurement
- Evaporation time measurement
4.7.3. Characterizations of the Film from Film-Forming Gel Base
- External appearances and film thickness
- Texture analysis
- Peel adhesion test
4.8. Development of Film-Forming Gel Containing Honey Aromatic Water with and without Royal Jelly
4.8.1. Preparation of Film-Forming Gel Base Containing Honey Aromatic Water with and without Royal Jelly
4.8.2. Characterizations of Film-Forming Gel Containing Honey Aromatic Water with and without Royal Jelly
4.8.3. Characterizations of the Film from Film-Forming Gel Containing Honey Aromatic Water with and without Royal Jelly
- External appearances and film thickness
- Micro-structural analysis
- Texture analysis
- Fourier transform infrared spectroscopy (FT-IR)
- X-ray diffraction (XRD) analysis
Supplementary Materials
Author Contributions
Funding
Data Availability Statement
Acknowledgments
Conflicts of Interest
References
- Kathe, K.; Kathpalia, H. Film forming systems for topical and transdermal drug delivery. Asian J. Pharm. Sci. 2017, 12, 487–497. [Google Scholar] [CrossRef] [PubMed]
- Kassa Degu, T.; Regasa Megerssa, G. Role of beekeeping in the community forest conservation: Evidence from Ethiopia. Bee World 2020, 97, 98–104. [Google Scholar] [CrossRef]
- Saudagar, R.B.; Gangurde, P.A. Formulation, development and evaluation of film-forming gel for prolonged dermal delivery of miconaole nitrate. Res. J. Top. Cos. Sci. 2017, 8, 19–29. [Google Scholar] [CrossRef]
- Sharma, R.; Rana, V. QbD steered fabrication of Pullulan-Terminalia catappa-Carbopol® 971P film forming gel for improved rheological, textural and biopharmaceutical aspects. Int. J. Biol. Macromol. 2021, 193, 1301–1312. [Google Scholar] [CrossRef]
- Partap, L.; Verma, L.R. Asian bees and beekeeping: Issues and initiatives. In Proceedings of the 4th Asian Apiculture Association International Conference, Kathmandu, Nepal, 23–28 March 1998. [Google Scholar]
- Abrol, D.P.; Shankar, U.; Nitin, K.S.; Gowda, G.B. Honeybees and beekeeping: The global scenario. In Arthropod Diversity and Conservation in the Tropics and Subtropics; Springer: Singapore, 2016; pp. 345–372. [Google Scholar]
- Scepankova, H.; Combarros-Fuertes, P.; Fresno, J.M.; Tornadijo, M.E.; Dias, M.S.; Pinto, C.A.; Saraiva, J.A.; Estevinho, L.M. Role of honey in advanced wound care. Molecules 2021, 26, 4784. [Google Scholar] [CrossRef]
- Kurek-Górecka, A.; Górecki, M.; Rzepecka-Stojko, A.; Balwierz, R.; Stojko, J. Bee products in dermatology and skin care. Molecules 2020, 25, 556. [Google Scholar] [CrossRef]
- Somwongin, S.; Chantawannakul, P.; Chaiyana, W. Antioxidant activity and irritation property of venoms from Apis species. Toxicon 2018, 145, 32–39. [Google Scholar] [CrossRef]
- Campos, M.G.; Bogdanov, S.; de Almeida-Muradian, L.B.; Szczesna, T.; Mancebo, Y.; Frigerio, C.; Ferreira, F. Pollen composition and standardisation of analytical methods. J. Apic. Res. 2008, 47, 154–161. [Google Scholar] [CrossRef]
- Ciucure, C.T.; Geană, E.I. Phenolic compounds profile and biochemical properties of honeys in relationship to the honey floral sources. Phytochem. Anal. 2019, 30, 481–492. [Google Scholar] [CrossRef]
- Ciulu, M.; Spano, N.; Pilo, M.I.; Sanna, G. Recent advances in the analysis of phenolic compounds in unifloral honeys. Molecules 2016, 21, 451. [Google Scholar] [CrossRef]
- Wang, Z.; Ren, P.; Wu, Y.; He, Q. Recent advances in analytical techniques for the detection of adulteration and authenticity of bee products—A review. Food Addit. Contam. Part A 2021, 38, 533–549. [Google Scholar] [CrossRef] [PubMed]
- Chuttong, B.; Chanbang, Y.; Sringarm, K.; Burgett, M. Physicochemical profiles of stingless bee (Apidae: Meliponini) honey from South east Asia (Thailand). Food Chem. 2016, 192, 149–155. [Google Scholar] [CrossRef] [PubMed]
- Saner, G.; Yercan, M.; Engindeniz, S.; Karaturhan, B.; Cukur, F. Alternative marketing strategies for honey and other bee products in Turkey. J. Agric. Food Inf. 2007, 8, 65–74. [Google Scholar] [CrossRef]
- Abramovič, H.; Jamnik, M.; Burkan, L.; Kač, M. Water activity and water content in Slovenian honeys. Food Control 2008, 19, 1086–1090. [Google Scholar] [CrossRef]
- Edwards, A.; Qi, S.; Liu, F.; Brown, M.B.; McAuley, W.J. Rationalising polymer selection for supersaturated film forming systems produced by an aerosol spray for the transdermal delivery of methylphenidate. Eur. J. Pharm. Biopharm. 2017, 114, 164–174. [Google Scholar] [CrossRef]
- Dos Santos, A.C.; Biluca, F.C.; Brugnerotto, P.; Gonzaga, L.V.; Costa, A.C.O.; Fett, R. Brazilian stingless bee honey: Physicochemical properties and aliphatic organic acids content. Food Res. Int. 2022, 158, 111516. [Google Scholar] [CrossRef]
- Pauliuc, D.; Dranca, F.; Oroian, M. Antioxidant Activity, Total Phenolic Content, Individual Phenolics and Physicochemical Parameters Suitability for Romanian Honey Authentication. Foods 2020, 9, 306. [Google Scholar] [CrossRef]
- Mato, I.; Huidobro, J.F.; Simal-Lozano, J.; Sancho, M.T. Rapid Determination of Nonaromatic Organic Acids in Honey by Capillary Zone Electrophoresis with Direct Ultraviolet Detection. J. Agric. Food Chem. 2006, 54, 1541–1550. [Google Scholar] [CrossRef]
- Mato, I.; Huidobro, J.F.; Simal-Lozano, J.; Sancho, M.T. Significance of Nonaromatic Organic Acids in Honey. J. Food Prot. 2003, 66, 2371–2376. [Google Scholar] [CrossRef]
- Nozal, M.J.; Bernal, J.L.; Gomez, L.A.; Higes, M.; Meana, A. Determination of oxalic acid and other organic acids in honey in some anatomic structures of bees. Apidologie 2003, 34, 181–188. [Google Scholar] [CrossRef]
- Tezcan, F.; Kolayli, S.; Ulusoy, H.S.E.; Erim, F.B. Evaluation of organic acid, saccharide composition and antioxidant properties of some authentic Turkish honeys. J. Food Nutr. Res. 2011, 50, 33–40. [Google Scholar]
- Hall-Stoodley, L.; Costerton, J.W.; and Stoodley, P. Bacterial biofilms: From the natural environment to infectious diseases. Nat. Rev. Microbiol. 2004, 2, 95–108. [Google Scholar] [CrossRef] [PubMed]
- Young, G.; Turner, S.; Davies, J.K.; Sundqvist, G.; Figdor, D. Bacterial DNA persists for extended periods after cell death. J. Endod. 2007, 33, 1417–1420. [Google Scholar] [CrossRef]
- Brueckner, D.; Roesti, D.; Zuber, U.G.; Schmidt, R.; Kraehenbuehl, S.; Bonkat, G.; Braissant, O. Comparison of tunable diode laser absorption spectroscopy and isothermal micro-calorimetry for non-invasive detection of microbial growth in media fills. Sci. Rep. 2016, 6, 27894. [Google Scholar] [CrossRef] [PubMed]
- Cheepa, F.F.; Liu, H.; Zhao, G. The natural cryoprotectant honey for fertility cryopreservation. Bioengineering 2022, 9, 88. [Google Scholar] [CrossRef] [PubMed]
- Aste, N.; Del Pero, C.; Leonforte, F. Active refrigeration technologies for food preservation in humanitarian context—A review. Sustain. Energy Technol. Assess. 2017, 22, 150–160. [Google Scholar] [CrossRef]
- Nishijima, M.; Tazato, N.; Handa, Y.; Tomita, J.; Kigawa, R.; Sano, C.; Sugiyama, J. Gluconacetobacter tumulisoli sp. nov., Gluconacetobacter takamatsuzukensis sp. nov. and Gluconacetobacter aggeris sp. nov., isolated from Takamatsuzuka Tumulus samples before and during the dismantling work in 2007. Int. J. Syst. Evol. Microbiol. 2013, 63, 3981–3988. [Google Scholar] [CrossRef]
- Dellaglio, F.; Cleenwerck, I.; Felis, G.E.; Engelbeen, K.; Janssens, D.; Marzotto, M. Description of Gluconacetobacter swingsii sp. nov. and Gluconacetobacter rhaeticus sp. nov., isolated from Italian apple fruit. Int. J. Syst. Evol. Microbiol. 2005, 55, 2365–2370. [Google Scholar] [CrossRef]
- Trček, J.; Mahnič, A.; Rupnik, M. Diversity of the microbiota involved in wine and organic apple cider submerged vinegar production as revealed by DHPLC analysis and next-generation sequencing. Int. J. Food Microbiol. 2016, 223, 57–62. [Google Scholar] [CrossRef]
- Yamada, Y. Systematics of acetic acid bacteria. In Acetic Acid Bacteria: Ecology and Physiology; Springer: Berlin/Heidelberg, Germany, 2016; pp. 1–50. [Google Scholar]
- Prado, A.; Barret, M.; Vaissière, B.E.; Torres-Cortes, G. Honey bees change the microbiota of pollen. Bot. Sci. 2023, 101, 127–133. [Google Scholar]
- Gomes, S.; Dias, L.G.; Moreira, L.L.; Rodrigues, P.; Estevinho, L. Physicochemical, microbiological and antimicrobial properties of commercial honeys from Portugal. Food Chem. Toxicol. 2010, 48, 544–548. [Google Scholar] [CrossRef] [PubMed]
- Luepke, N.P.; Kemper, F.H. The HET-CAM test: An alternative to the Draize eye test. Food Chem. Toxicol. 1986, 24, 495–496. [Google Scholar] [CrossRef]
- Ma, Q.; Du, L.; Yang, Y.; Wang, L. Rheology of film-forming solutions and physical properties of tara gum film reinforced with polyvinyl alcohol (PVA). Food Hydrocoll. 2017, 63, 677–684. [Google Scholar] [CrossRef]
- Syakri, S.; Ismail, I.; Amal, N.M.; Masjidi, N.A.; Tahir, K.A. Characterization and anti-aging tests of peel-off gel masks made from ethanolic extract of Yarrow (Achillea millefolium). Open Access Maced. J. Med. Sci. 2021, 9, 1156–1161. [Google Scholar] [CrossRef]
- Apriani, E.F.; Miksusanti, M.; Fransiska, N. Formulation and optimization peel-off gel mask with polyvinyl alcohol and gelatin based using factorial design from banana peel flour (Musa paradisiaca L.) as antioxidant. Indones. J. Pharm. 2022, 33, 261–268. [Google Scholar] [CrossRef]
- Proksch, E. pH in nature, humans and skin. J. Dermatol. 2018, 45, 1044–1052. [Google Scholar] [CrossRef]
- Lambers, H.; Piessens, S.; Bloem, A.; Pronk, H.; Finkel, P. Natural skin surface pH is on average below 5, which is beneficial for its resident flora. Int. J. Cosmet. Sci. 2006, 28, 359–370. [Google Scholar] [CrossRef]
- Souza, L.K.; Bruno, C.H.; Lopes, L.; Pulcinelli, S.H.; Santilli, C.V.; Chiavacci, L.A. Ureasil–polyether hybrid film-forming materials. Colloids Surf. B Biointerfaces 2013, 101, 156–161. [Google Scholar] [CrossRef]
- Nursal, F.K.; Rahmani, A. Effect of Glycerin as Plasticizer in Formulation of Grape Seed Oil (Vitis vinifera L.) Emulgel Peel-Off Mask. In IOP Conference Series: Earth and Environmental Science; IOP Publishing: Bristol, UK, 2021; p. 012058. [Google Scholar]
- Rowe, R.C.; Sheskey, P.; Quinn, M. Polyvinyl alcohol. In Handbook of Pharmaceutical Excipients, 6th ed.; Libros Digitales-Pharmaceutical Press: London, UK, 2009; pp. 564–565. [Google Scholar]
- Rowe, R.C.; Sheskey, P.; Quinn, M. Carboxymethylcellulose sodium. In Handbook of Pharmaceutical Excipients, 6th ed.; Libros Digitales-Pharmaceutical Press: London, UK, 2009; pp. 118–121. [Google Scholar]
- Rowe, R.C.; Sheskey, P.; Quinn, M. Hydroxyethyl cellulose. In Handbook of Pharmaceutical Excipients, 6th ed.; Libros Digitales-Pharmaceutical Press: London, UK, 2009; pp. 311–314. [Google Scholar]
- Ghose, A.; Nabi, B.; Rehman, S.; Md, S.; Alhakamy, N.A.; Ahmad, O.A.; Baboota, S.; Ali, J. Development and evaluation of polymeric nanosponge hydrogel for terbinafine hydrochloride: Statistical optimization, in vitro and in vivo studies. Polymers 2020, 12, 2903. [Google Scholar] [CrossRef]
- Sahinler, N.; Sahinler, S. Effects of the number of queen cells and harvesting interval on the acceptance rates of the larvae, royal jelly quality and quantity. J. Vet. Anim. Sci. 2002, 1, 120–122. [Google Scholar]
- Boukraa, L. Additive activity of royal jelly and honey against Pseudomonas aeruginosa. Altern. Med. Rev. 2008, 13, 330–333. [Google Scholar] [PubMed]
- Singh, S.; Chunglok, W.; Nwabor, O.F.; Ushir, Y.V.; Singh, S.; Panpipat, W. Hydrophilic biopolymer matrix antibacterial peel-off facial mask functionalized with biogenic nanostructured material for cosmeceutical applications. J. Polym. Environ. 2022, 30, 938–953. [Google Scholar] [CrossRef]
- Ghanbarzadeh, B.; Almasi, H.; Entezami, A.A. Improving the barrier and mechanical properties of corn starch-based edible films: Effect of citric acid and carboxymethyl cellulose. Ind. Crops Prod. 2011, 33, 229–235. [Google Scholar] [CrossRef]
- Seki, Y.; Altinisik, A.; Demircioğlu, B.; Tetik, C. Carboxymethylcellulose (CMC)–hydroxyethylcellulose (HEC) based hydrogels: Synthesis and characterization. Cellulose 2014, 21, 1689–1698. [Google Scholar] [CrossRef]
- Jain, N.; Sharma, P.; Verma, A.; Gupta, J. Enhancement of thermo-mechanical, creep-recovery, and anti-microbial properties in PVA-based biodegradable films through cross-linking with oxalic acid: Implications for packaging application. Biomass Convers. Biorefin. 2023, 1–10. [Google Scholar] [CrossRef]
- Takigami, M.; Amada, H.; Nagasawa, N.; Yagi, T.; Kasahara, T.; Takigami, S.; Tamada, M. Preparation and properties of CMC gel. Trans. Mater. Res. Soc. Jpn. 2007, 32, 713–716. [Google Scholar] [CrossRef]
- Nasatto, P.L.; Pignon, F.; Silveira, J.L.; Duarte, M.E.R.; Noseda, M.D.; Rinaudo, M. Methylcellulose, a cellulose derivative with original physical properties and extended applications. Polymers 2015, 7, 777–803. [Google Scholar] [CrossRef]
- Pavel, C.I.; Mărghitaş, L.A.; Bobiş, O.; Dezmirean, D.S.; Şapcaliu, A.; Radoi, I.; Mădaş, M.N. Biological activities of royal jelly-review. J. Anim. Sci. Biotechnol. 2011, 44, 108–118. [Google Scholar]
- Kurth, T.; Kretschmar, S.; Buttstedt, A. Royal jelly in focus. Insectes Soc. 2019, 66, 81–89. [Google Scholar] [CrossRef]
- Patra, T.; Pal, A.; Dey, J. Birefringent physical gels of N-(4-n-alkyloxybenzoyl)-l-alanine amphiphiles in organic solvents: The role of hydrogen-bonding. J. Colloid Interface Sci. 2010, 344, 10–20. [Google Scholar] [CrossRef]
- Jilal, I.; El Barkany, S.; Bahari, Z.; Sundman, O.; El Idrissi, A.; Abou-Salama, M.; Romane, A.; Zannagui, C.; Amhamdi, H. New quaternized cellulose based on hydroxyethyl cellulose (HEC) grafted EDTA: Synthesis, characterization and application for Pb (II) and Cu (II) removal. Carbohydr. Polym. 2018, 180, 156–167. [Google Scholar] [CrossRef]
- Tongdeesoontorn, W.; Mauer, L.J.; Wongruong, S.; Sriburi, P.; Rachtanapun, P. Effect of carboxymethyl cellulose concentration on physical properties of biodegradable cassava starch-based films. Chem. Cent. J. 2011, 5, 6. [Google Scholar] [CrossRef] [PubMed]
- Adel, A.M.; Abou-Youssef, H.; El-Gendy, A.A.; Nada, A.M. Carboxymethylated cellulose hydrogel; sorption behavior and characterization. Nat. Sci. 2010, 8, 244–256. [Google Scholar]
- El-Sayed, N.S.; Awad, H.; El-Sayed, G.M.; Nagieb, Z.A.; Kamel, S. Synthesis and characterization of biocompatible hydrogel based on hydroxyethyl cellulose-g-poly (hydroxyethyl methacrylate). Polym. Bull. 2020, 77, 6333–6347. [Google Scholar] [CrossRef]
- Abral, H.; Atmajaya, A.; Mahardika, M.; Hafizulhaq, F.; Handayani, D.; Sapuan, S.M.; Ilyas, R.A. Effect of ultrasonication duration of polyvinyl alcohol (PVA) gel on characterizations of PVA film. J. Mater. Res. Technol. 2020, 9, 2477–2486. [Google Scholar] [CrossRef]
- Achachlouei, B.F.; Zahedi, Y. Fabrication and characterization of CMC-based nanocomposites reinforced with sodium montmorillonite and TiO2 nanomaterials. Carbohydr. Polym. 2018, 199, 415–425. [Google Scholar] [CrossRef]
- Hassan, M.A.; Omer, A.M.; Abbas, E.; Baset, W.M.; Tamer, T.M. Preparation, physicochemical characterization and antimicrobial activities of novel two phenolic chitosan Schiff base derivatives. Sci. Rep. 2018, 8, 11416. [Google Scholar] [CrossRef]
- Gilleron, L.; Coecke, S.; Sysmans, M.; Hansen, E.; Van Oproy, S.; Marzin, D.; Cauteren, H.V.; Vanparys, P. Evaluation of a modified HET-CAM assay as a screening test for eye irritancy. Toxicol. In Vitro 1996, 10, 431–446. [Google Scholar] [CrossRef]
- Öztürk, A.A.; Yenilmez, E.; Şenel, B.; Kıyan, H.T.; Güven, U.M. Effect of different molecular weight PLGA on flurbiprofen nanoparticles: Formulation, characterization, cytotoxicity, and in vivo anti-inflammatory effect by using HET-CAM assay. Drug Dev. Ind. Pharm. 2020, 46, 682–695. [Google Scholar] [CrossRef]
- Bachhav, Y.G.; Patravale, V.B. Microemulsion based vaginal gel of fluconazole: Formulation, in vitro and in vivo evaluation. Int. J. Pharm. 2009, 365, 175–179. [Google Scholar] [CrossRef]
- Cilurzo, F.; Minghetti, P.; Sinico, C. Newborn pig skin as model membrane in in vitro drug permeation studies: A technical note. AAPS PharmSciTech 2007, 8, 97–100. [Google Scholar] [CrossRef] [PubMed]
- Thouless, M.D.; Yang, Q.D. A parametric study of the peel test. Int. J. Adhes. Adhes. 2008, 28, 176–184. [Google Scholar]
- Qi, G.; Sun, X.S. Peel adhesion properties of modified soy protein adhesive on a glass panel. Ind. Crops Prod. 2010, 32, 208–212. [Google Scholar] [CrossRef]

| Isolate Code | Accession NO. | Size of Nucleic Acid (bp) | Closet Match Species | Identity (%) |
|---|---|---|---|---|
| HAW01 | NR_114382.1 | 1414 | Gluconacetobacter aggeris | 100 |
| Samples | Irritation Score | Irritation Potency |
|---|---|---|
| Positive control (1% w/v SLS) | 11.81 ± 0.19 | Severe irritation |
| Negative control (0.9% w/v NaCl) | 0.00 ± 0.00 | No irritation |
| Autoclaved honey aromatic water | 0.00 ± 0.00 | No irritation |
| Filtered honey aromatic water | 0.00 ± 0.00 | No irritation |
| Parameters | Film-Forming Gel Base Formulations | ||||||
|---|---|---|---|---|---|---|---|
| 1 | 2 | 3 | 4 | 5 | 6 | 7 | |
| Film-forming gel | |||||||
| Viscosity (mPa·s) | 0.27 ± 0.01 f | 0.75 ± 0.02 e | 1.91 ± 0.08 c | 0.81 ± 0.03 e | 2.24 ± 0.13 b | 1.26 ± 0.01 d | 4.43 ± 0.04 a |
| Spreadability (cm) | 11.5 ± 0.7 a | 4.7 ± 0.5 c | 2.9 ± 0.1 d | 5.7 ± 0.2 b | 3.4 ± 0.2 d | 4.5 ± 0.1 c | 3.1 ± 0.1 d |
| pH | 4.5 | 5.5 | 5.5 | 4.5 | 4.5 | 5.0 | 5.0 |
| Drying time (min) | |||||||
| on glass slide | 85.3 ± 0.6 c | 88.3 ± 0.6 b | 74.3 ± 1.6 a | 59.3 ± 1.2 f | 62.7 ± 0.6 e | 73.3 ± 1.2 d | 73.7 ± 0.6 d |
| on piglet skin | 22.3 ± 1.1 b | 22.6 ± 0.6 b | 25.3 ± 1.3 a | 19.5 ± 1.1 c,d | 19.6 ± 0.6 c,d | 19.4 ± 0. 6 d | 21.9 ± 0.3 b,c |
| Film | |||||||
| Tensile strength (N/mm2) | ND | 5.52 ± 1.69 c | 13.52 ± 0.54 a,b | 3.18 ± 0.24 c | 4.29 ± 0.11 c | 11.05 ± 2.54 b | 15.69 ± 0.89 a |
| Elongation (%) | ND | 4.29 ± 0.00 c | 2.86 ± 0.00 c | 2.86 ± 0.00 c | 5.00 ± 1.01 b,c | 9.29 ± 1.01 a | 7.14 ± 2.02 a,b |
| Young’s modulus (kPa) | ND | 1.29 ± 0.39 c | 4.73 ± 0.19 a | 1.11 ± 0.08 c | 0.87 ± 0.15 c | 1.18 ± 0.14 c | 2.27 ± 0.52 b |
| Adhesion (N/mm) | ND | 53.5 ± 14.5 a | N/A | N/A | 20.8 ± 1.9 b | 19.8 ± 1.0 b | 30.1 ± 7.6 b |
| Parameters | Film-Forming Gel Containing Honey Aromatic Water with and without Royal Jelly | ||||
|---|---|---|---|---|---|
| 6 | 6A | 6R0.5 | 6R1 | 6R2 | |
| Film-forming gel | |||||
| Viscosity (mPa·s) | 1.26 ± 0.01 a | 0.91 ± 0.02 c | 0.66 ± 0.03 e | 0.75 ± 0.05 d | 1.10 ± 0.03 b |
| Spreadability (cm) | 4.5 ± 0.1 c | 5.3 ± 0.0 b | 5.9 ± 0.3 a | 4.4 ± 0.2 c | 4.9 ± 0.1 b,c |
| pH | 5.0 | 4.5 | 4.5 | 4.5 | 4.5 |
| Drying time (min) | |||||
| on glass slide | 73.3 ± 1.2 a | 47.7 ± 0.6 c | 51.6 ± 0.6 b | 49.7 ± 1.6 b | 47.0 ± 1.0 c |
| on piglet skin | 19.4 ± 0.6 a | 17.4 ± 0.1 b | 14.7 ± 0.6 c | 10.4 ± 0.6 d | 18.4 ± 1.0 a,b |
| Film | |||||
| Tensile strength (kg/cm2) | 11.05 ± 2.54 a | 5.51 ± 0.58 c | 7.53 ± 0.81 b,c | 10.15 ± 0.76 a,b | 9.13 ± 0.07 a,b |
| Elongation (%) | 9.29 ± 1.01 a | 7.14 ± 0.00 b | 10.00 ± 4.04 a | 10.00 ± 0.00 a | 4.29 ± 0.00 c |
| Young’s modulus (mPa) | 1.18 ± 0.14 b | 0.77 ± 0.08 c | 0.80 ± 0.24 c | 1.02 ± 0.08 b,c | 2.13 ± 0.02 a |
| Adhesion (N/mm) | 19.8 ± 1.0 a | 2.1 ± 0.0 b | 1.6 ± 0.5 b | 2.5 ± 1.4 b | 19.8 ± 2.0 a |
| Ingredients | Amount (% w/w) | ||||||
|---|---|---|---|---|---|---|---|
| 1 | 2 | 3 | 4 | 5 | 6 | 7 | |
| PVA 117 | 3 | 3 | 3 | 3 | 3 | 3 | 3 |
| CMC | - | 1 | 2 | - | - | 0.5 | 1 |
| HEC | - | - | - | 1 | 2 | 0.5 | 1 |
| PEG 400 | 5 | 5 | 5 | 5 | 5 | 5 | 5 |
| DI water | 92 | 91 | 90 | 91 | 90 | 91 | 90 |
| Ingredients | Amount (% w/w) | ||||
|---|---|---|---|---|---|
| 6 | 6A | 6R0.5 | 6R1 | 6R2 | |
| Honey aromatic water | - | 91 | 90.5 | 90 | 89 |
| Royal jelly | - | - | 0.5 | 1 | 2 |
| PVA 117 | 3 | 3 | 3 | 3 | 3 |
| CMC | 0.5 | 0.5 | 0.5 | 0.5 | 0.5 |
| HEC | 0.5 | 0.5 | 0.5 | 0.5 | 0.5 |
| PEG 400 | 5 | 5 | 5 | 5 | 5 |
| DI water | 91 | - | - | - | - |
Disclaimer/Publisher’s Note: The statements, opinions and data contained in all publications are solely those of the individual author(s) and contributor(s) and not of MDPI and/or the editor(s). MDPI and/or the editor(s) disclaim responsibility for any injury to people or property resulting from any ideas, methods, instructions or products referred to in the content. |
© 2023 by the authors. Licensee MDPI, Basel, Switzerland. This article is an open access article distributed under the terms and conditions of the Creative Commons Attribution (CC BY) license (https://creativecommons.org/licenses/by/4.0/).
Share and Cite
Thewanjutiwong, S.; Phokasem, P.; Disayathanoowat, T.; Juntrapirom, S.; Kanjanakawinkul, W.; Chaiyana, W. Development of Film-Forming Gel Formulations Containing Royal Jelly and Honey Aromatic Water for Cosmetic Applications. Gels 2023, 9, 816. https://doi.org/10.3390/gels9100816
Thewanjutiwong S, Phokasem P, Disayathanoowat T, Juntrapirom S, Kanjanakawinkul W, Chaiyana W. Development of Film-Forming Gel Formulations Containing Royal Jelly and Honey Aromatic Water for Cosmetic Applications. Gels. 2023; 9(10):816. https://doi.org/10.3390/gels9100816
Chicago/Turabian StyleThewanjutiwong, Sirawut, Patcharin Phokasem, Terd Disayathanoowat, Saranya Juntrapirom, Watchara Kanjanakawinkul, and Wantida Chaiyana. 2023. "Development of Film-Forming Gel Formulations Containing Royal Jelly and Honey Aromatic Water for Cosmetic Applications" Gels 9, no. 10: 816. https://doi.org/10.3390/gels9100816
APA StyleThewanjutiwong, S., Phokasem, P., Disayathanoowat, T., Juntrapirom, S., Kanjanakawinkul, W., & Chaiyana, W. (2023). Development of Film-Forming Gel Formulations Containing Royal Jelly and Honey Aromatic Water for Cosmetic Applications. Gels, 9(10), 816. https://doi.org/10.3390/gels9100816

